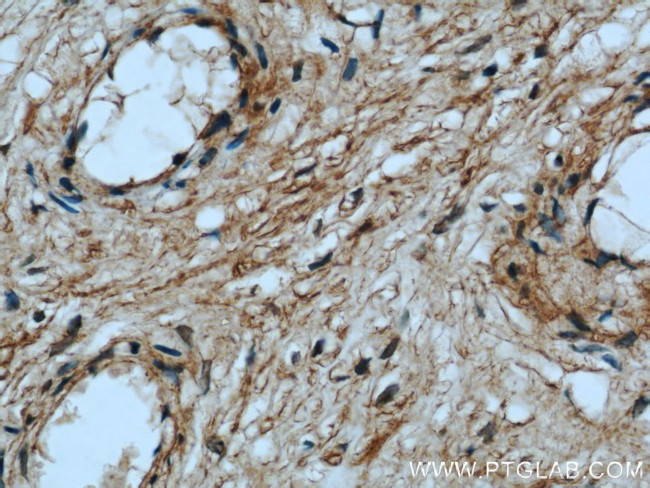
BCAT2 Antibody in Immunohistochemistry (Paraffin) (IHC (P))

Search
Proteintech
BCAT2 Polyclonal Antibody
{{$productOrderCtrl.translations['antibody.pdp.commerceCard.promotion.promotions']}}
{{$productOrderCtrl.translations['antibody.pdp.commerceCard.promotion.viewpromo']}}
{{$productOrderCtrl.translations['antibody.pdp.commerceCard.promotion.promocode']}}: {{promo.promoCode}} {{promo.promoTitle}} {{promo.promoDescription}}. {{$productOrderCtrl.translations['antibody.pdp.commerceCard.promotion.learnmore']}}
产品信息
16417-1-AP
种属反应
已发表种属
宿主/亚型
分类
类型
抗原
偶联物
形式
浓度
规格
纯化类型
保存液
内含物
保存条件
运输条件
产品详细信息
Immunogen sequence: MTQKPHKKP GPGEPLVFGK TFTDHMLMVE WNDKGWGQPR IQPFQNLTLH PASSSLHYSL QLFEGMKAFK GKDQQVRLFR PWLNMDRMLR SAMRLCLPSF DKLELLECIR RLIEVDKDWV PDAAGTSLYV RPVLIGNEPS LGVSQPTRAL LFVILCPVGA YFPGGSVTPV SLLADPAFIR AWVGGVGNYK LGGNYGPTVL VQQEALKRGC EQVLWLYGPD HQLTEVGTMN IFVYWTHEDG VLELVTPPLN GVILPGVVRQ SLLDMAQTWG EFRVVERTIT MKQLLRALEE GRVREVFGSG TACQVCPVHR ILYKDRNLHI PTMENGPELI LRFQKELKEI QYGIRAHEWM FPV (41-392 aa encoded by BC001900)
靶标信息
This gene encodes a branched chain aminotransferase found in mitochondria. The encoded protein forms a dimer that catalyzes the first step in the production of the branched chain amino acids leucine, isoleucine, and valine. Multiple transcript variants encoding different isoforms have been found for this gene.
仅用于科研。不用于诊断过程。未经明确授权不得转售。
生物信息学
蛋白别名: BCAT; BCAT(m); branched chain amino-acid transaminase 2, mitochondrial; branched chain aminotransferase 2, mitochondrial; Branched-chain-amino-acid aminotransferase, mitochondrial; Placental protein 18; PP18; PP18a; mitochondrial branched chain aminotransferase; PP18b; cytosolic branched chain aminotransferase; unnamed protein product
基因别名: BCAM; BCAT2; BCATM; BCT2; ECA40; HVLI; PP18
UniProt ID: (Human) O15382
Entrez Gene ID: (Human) 587